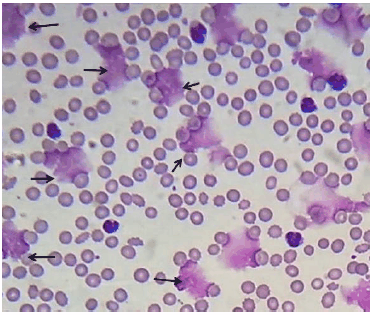
Enunciado 3137088-1

Foram encontradas 60 questões.
O tratamento primário dos pacientes portadores de beta-talassemia/talassemia major é a hipertransfusão.
Assinale a opção que corresponde ao tipo de concentrado de hemácias que deve ser utilizado para esses pacientes.
Provas
Um dos efeitos adversos mais frequentes da doação de sangue são as reações vasovagais.
Assinale a opção que indica o procedimento a ser inicialmente adotado no tratamento dessa complicação.
Provas
Os critérios para a inaptidão de candidatos a doadores de sangue são definidos em normas e portarias federais. A respeito desses critérios, analise as afirmativas a seguir.
I. Homens trans não podem ser aceitos para a doação de sangue.
II. Homens que tiveram relação sexual com outro(s) homem (ns) ficam inaptos para a doação por um período de três meses após a última relação sexual deste tipo.
III. Pessoas que fazem uso de cocaína intranasal ficam inaptos para a doação por um período de 12 meses, a contar da data do último uso da droga.
Está correto o que se afirma em
Provas
Um paciente portador de hemofilia A grave, 30 anos de idade, e 80 kg de peso, faz apenas tratamento de demanda, com fator VIII recombinante, sofreu um acidente automobilístico que resultou em fratura da bacia. A fratura precisará ser abordada cirurgicamente.
Assinale a opção que reflete a orientação do Ministério da Saúde para a reposição de fator VIII no pré-operatório imediato e nos 3 primeiros dias de pós-operatório.
Provas
Um paciente de 36 anos que apresentou trombose venosa profunda na perna, com embolia pulmonar, começou a receber, diariamente, anticoagulante de ação direta (Dabigratana). Após três meses de uso do medicamento, o paciente teve uma hemorragia digestiva de grande vulto, requerendo transfusão maciça.
Escolha, dentre as opções listadas a seguir, aquela que contém o antídoto para reversão imediata da anticoagulação desse paciente.
Provas
Relacione as características da Doença de von Willebrand ao respectivo tipo da doença.
1. Teor de fator de von Willebrand: antígeno muito baixo ou ausente e teor de fator VIII <5%.
2. Teor de fator de von Willebrand: antígeno normal e teor de cofator de ristocetina muito baixo.
3. Teor de fator de von Willebrand: antígeno e de cofator de ristocetina baixos.
4. Teor de cofator de ristocetina baixo e agregação plaquetária com ristocetina aumentada.
( ) Tipo 3
( ) Tipo 2B
( ) Tipo 2A
( ) Tipo 1
Assinale a opção que mostra a relação correta, na ordem apresentada.
Provas
Em relação à transfusão profilática de plaquetas no pré-operatório imediato de pacientes portadores de anemia aplástica, que serão submetidos à cirurgia para correção de deslocamento de retina, assinale a afirmativa correta.
Provas
Assinale a opção que corresponde ao tratamento da hemoglobinúria paroxística noturna (HPN).
Provas
Observe atentamente o esfregaço sanguíneo a seguir.
Assinale a opção que corresponde aos artefatos assinalados pelas setas.
Provas
Em relação aos efeitos colaterais da terapia com imunoglobulina poliesespecífica intravenosa, relacione a reação adversa ao tipo de medida que pode prevenir o efeito adverso.
1. Meningite asséptica
2. Insuficiência renal aguda
3. Hemólise
4. Trombose
( ) Altas doses
( ) Teor excessivo de fator XI no produto
( ) Uso de imunoglobulinas contendo açúcar na sua formulação
( ) Teor excessivo de aglutininas anti-A e anti-B no produto
Assinale a opção que apresenta a relação correta, na ordem apresentada.
Provas
Caderno Container